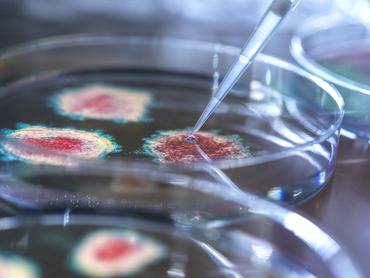

Előremenekül az EU: iszonyatos összeget szánnak az újgenerációs oltásokra
Az Európai Bizottság több mint 200 millió eurót fektet az újgenerációs influenzavakcinák fejlesztésébe.A források olyan orron, szájon át vagy bőrre helyezhető tapasz formájában alkalmazható szerek kidolgozását támogatják, amelyek vészhelyzet esetén gyorsan, nagy mennyiségben gyárthatók, és nem kell hozzá tűszúrás.